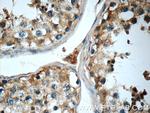
Cryptochrome 1 Antibody in Immunohistochemistry (Paraffin) (IHC (P))

Search
Proteintech
Cryptochrome 1 Polyclonal Antibody
{{$productOrderCtrl.translations['antibody.pdp.commerceCard.promotion.promotions']}}
{{$productOrderCtrl.translations['antibody.pdp.commerceCard.promotion.viewpromo']}}
{{$productOrderCtrl.translations['antibody.pdp.commerceCard.promotion.promocode']}}: {{promo.promoCode}} {{promo.promoTitle}} {{promo.promoDescription}}. {{$productOrderCtrl.translations['antibody.pdp.commerceCard.promotion.learnmore']}}
产品信息
13474-1-AP
种属反应
已发表种属
宿主/亚型
分类
类型
抗原
偶联物
形式
浓度
规格
纯化类型
保存液
内含物
保存条件
运输条件
产品详细信息
Immunogen sequence: RPRMNANSL LASPTGLSPY LRFGCLSCRL FYFKLTDLYK KVKKNSSPPL SLYGQLLWRE FFYTAATNNP RFDKMEGNPI CVQIPWDKNP EALAKWAEGR TGFPWIDAIM TQLRQEGWIH HLARHAVACF LTRGDLWISW EEGMKVFEEL LLDADWSINA GSWMWLSCSS FFQQFFHCYC PVGFGRRTDP NGDYIRRYLP VLRGFPAKYI YDPWNAPEGI QKVAKCLIGV NYPKPMVNHA EASRLNIERM KQIYQQLSRY RGLGLLASVP SNPNGNGGFM GYSAENIPGC SSSGSCSQGS GILHYAHGDS QQTHLLKQGR SSMGTGLSGG KRPSQEEDTQ SIGPKVQRQS TN (236-586 aa encoded by BC030519)
靶标信息
Various biochemical, physiological and behavioral processes display circadian rhythms controlled by an internal biological clock. The central "gears" driving this clock appear to be composed of an autoregulatory transcription/post translation-based feedback loop. Cryptochrome 1 (CRY1) and 2 (CRY2) are DNA-binding flavoproteins that bear some homology to blue-light receptors and photolyases. In Drosophila, CRY is a photoreceptor for the circadian clock where it binds to the clock component TIM in a light-dependent fashion and blocks its function. Mammalian CRY1 and CRY2 function via light-independent interactions with circadian genes CLOCK and BMAL1, as well as with PER1, PER2, and TIM. They seem to act as light-independent components of the circadian clock and likely regulate Per1 transcriptional cycling via interactions with both the activator and its feedback inhibitors. Mutant mice not expressing the Cry1 or Cry2 protein display accelerated and delayed periodicity of locomotor activity, respectively. It appears that the combination of both proteins working together is essential to synchronize the organism to circadian phases. A critical balance between Cry1 and Cry2 is required for proper clock function; in complete darkness, double-mutant mice present with instantaneous arrhythmicity, indicating the absence of an internal circadian clock.
仅用于科研。不用于诊断过程。未经明确授权不得转售。
生物信息学
蛋白别名: ATCRY1; BLU1; BLUE LIGHT PHOTORECEPTOR; BLUE LIGHT UNINHIBITED 1; cryptochrome 1 (photolyase-like); CRYPTOCHROME 1 APOPROTEIN; cryptochrome circadian clock 1; Cryptochrome-1; ELONGATED HYPOCOTYL 4; HY4; OOP2; OUT OF PHASE 2; T3H13.14; T3H13_14; unnamed protein product
基因别名: AU020726; AU021000; CRY1; DSPD; PHLL1
UniProt ID: (Human) Q16526, (Rat) Q32Q86, (Mouse) P97784
Entrez Gene ID: (Human) 1407, (Rat) 299691, (Mouse) 12952